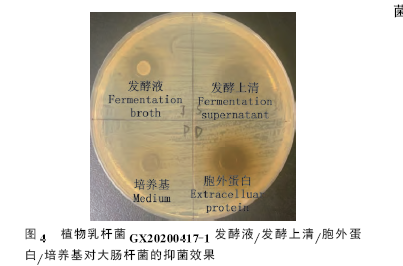
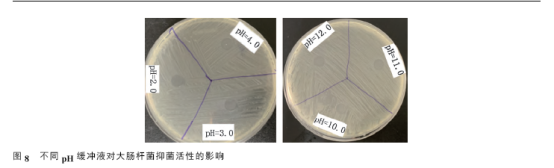

植物乳桿菌是一種多功能乳酸菌,作為乳酸菌的代表,在自然界分布廣泛。因其具有良好的抗菌性能而成為無抗養殖領域的研究重點,是一類具有開發前景的新型綠色抗菌制劑。
現有研究表明,植物乳桿菌的抗菌特性主要依賴于其產生的代謝產物,分離到的抑菌物質主要包括有機酸、脂肪酸、抑菌蛋白或小分子抗菌肽,抑菌蛋白或小分子抗菌肽是植物乳桿菌產生的重要代謝產物,研究證實植物乳桿菌的發酵上清經蛋白酶處理后,其原本的抑菌能力將會大打折扣。目前針對植物乳桿菌抑菌蛋白的研究主要集中在對其進行分離、鑒定及其抑菌機理的探討。詹暉等對小鼠進行沙門氏菌攻毒,發現植物乳桿菌細菌素對沙門氏菌在增殖過程中的細胞膜有破壞作用。韓金志等從植物乳桿菌中分離出一種新型細菌素,經抑菌試驗證實其對大腸桿菌、鼠傷寒沙門氏菌、金黃色葡萄球菌等食源性致病菌具有不同程度的抑菌活性。細菌素可破壞病原菌的細胞膜或細胞壁,使其內容物外泄而達到抑菌作用,也可以菌體的核酸為作用靶點,阻礙病原菌的增殖分裂從而發揮抗菌作用。Miao等研究發現干酪乳桿菌的細菌素F1可通過作用于金黃色葡萄球菌的DNA和破壞細胞膜兩種方式抑制金黃色葡萄球菌的增殖。Khalaf等從乳酸菌中分離出的細菌素PLNC8αβ可通過破壞病原菌的生物膜從而發揮抗菌作用。
與其他非蛋白類抑菌物質相比,抑菌蛋白或小分子抗菌肽抑菌活性強,抑菌譜廣且抑菌蛋白編碼基因易克隆表達,可為實現工業化生產發揮更大的應用價值。篩選新型廣譜而有效的抑菌蛋白或小分子抗菌肽可為開發新型替抗產品提供新思路新選擇。目前針對植物乳桿菌的抑菌效果研究多集中在有機酸的協同作用,而對于抗菌肽或抑菌蛋白的協同作用卻鮮有報道。本研究通過低溫離心和超濾法提取植物乳桿菌代謝產物中的胞外蛋白,采用液相色譜串聯質譜(LC-MS/MS)法進一步分析鑒定抑菌蛋白成分,并對抑菌機制進行解析,以期為全面解析植物乳桿菌的抑菌機制和進一步研發替代抗生素的新一代綠色安全抑菌蛋白制劑提供參考。
1 材料與方法
1.1 材料
1.1.1 菌株與培養基
試驗用菌種植物乳桿菌GX20200417-1.分離自廣西市售發酵酸菜,由廣西壯族自治區獸醫研究所細菌室提供;指示菌大腸桿菌ATCC25922、金黃色葡萄球菌ATCC 6583、沙門氏菌SM022均由廣西壯族自治區獸醫研究所收藏保存。MRS肉湯培養基購自北京陸橋技術股份有限公司。
1.1.2 主要試劑及儀器
RIPA裂解液(Solarbio公司);乙腈(ACN)、 甲酸(FA) 、碳酸氫銨、二硫蘇糖醇(DTT)、碘乙酰胺(IAA)(Sigma-Aldrich公司);考馬斯亮藍染色劑(碧云天生物技術有限公司)。超凈工作臺(Thermo Scientific公司);低溫高速離心機(Eppendorf公司);Western電泳儀(Bio-Rad公司);毛細管高效液相色譜儀和電噴霧組合型離子阱Orbitrap質譜儀(Thermo Fisher Scientific公司)
1.2 方法
1.2.1 菌種活化及生長性能測定
將-80℃保存的菌種溶解,灼燒接種環至冷卻后,蘸取少量菌液,輕輕劃線接種于指定的平板培養基,37℃培養24h后,挑取單個菌落,接種于MRS 液體培養基,37℃、150r/min恒溫搖床震蕩培養,分別在0、4、8、12、24、36和48h吸取發酵液,測定其D600nm值。
1.2.2 植物乳桿菌發酵上清液的制備
將活化傳代后的植物乳桿菌接種于15mL MRS液體培養基,37℃、150r/min恒溫搖床震蕩培養24h后,4℃、12000r/min離心10min,取上清液經0.22 μm無菌濾膜過濾,并收集濾液。
1.2.3 牛津杯法檢測抑菌活性
分別吸取200μL 1×108CFU/mL的指示菌懸液并均勻涂布于固體培養板上,輕輕放置牛津杯,在杯中加入200μL發酵液/發酵上清液/胞外蛋白,37℃恒溫培養24h,每種處理做3個平行,測定抑菌圈直徑。
1.2.4 不同培養時間植物乳桿菌發酵上清液對大腸桿菌抑菌活性的測定
將活化的植物乳桿菌接種于15mL MRS液體培養基37℃、150r/min恒溫搖床震蕩培養,分別在培養0、4、8、12、24、36和48h時吸取200μl發酵液按照1.2.2的方法收集發酵上清液按照1.2.3的方法測定其對于大腸桿菌的抑菌活性。
1.2.5 胞外蛋白的制備
將1.2.2收集到的發酵上清液加入到3ku超濾膜的15mL超濾管中,4℃、6500r/min離心40min收集濃縮液,并將濃縮液稀釋于MRS培養基中,使其蛋白溶液總量與初始發酵液體積一致。
1.2.6 SDS-PAGE分離胞外蛋白
取適量胞外蛋白樣品,與Loading Buffer(5×)混合,將樣品和Marker依次加入12%分離凝膠的孔中,100V運行10min。然后120V運行60min,剝離膠放入考馬斯亮藍染色液中,室溫染色1h。加入脫色液,置于80r/min脫色搖床上,每20m更換一次脫色液至完全脫凈。完成脫色后,用雙蒸水浸泡,參照蛋白質分子質量標準將所提純的蛋白從凝膠中分離出來。
1. 2.7 抑菌蛋白理化特性研究
1.2.7.1 溫度對抑菌蛋白抑菌活性的影響
將抑菌蛋白分別在20、40、60、80、100和121℃下水浴30min,以室溫的抑菌蛋白液為對照組,每組3個重復,采用牛津杯法測定不同處理后的樣品對大腸桿菌抑菌活性的影響。
1.2.7.2 pH對抑菌蛋白抑菌活性的影響
將抑菌蛋白分別用Tris-HCI和MES-NaOH緩沖液調節pH至2.0、4.0、6.0、8.0、10.0、11.0和12.0.靜置2h.以未處理的抑菌蛋白液為對照組,每組3個重復,采用牛津杯法測定不同處理后的樣品對大腸桿菌抑菌活性的影響。
無菌蒸餾水分別用Tris-HCI和MES-NaOH緩沖液調節pH至2.0、3.0、4.0、10.0、11.0和12.0.采用牛津杯法測定不同pH緩沖液對大腸桿菌抑菌活性的影響,以排除過酸或過堿條件本身對抑菌效果的影響。
1.2. 7. 3 蛋白酶對抑菌蛋白抑菌活性的影響
分別用胰蛋白酶與蛋白酶K處理抑菌蛋白,37℃水浴30min,以未處理的抑菌蛋白液為對照組,每組3個重復,采用牛津杯法測定不同處理后的樣品對大腸桿菌抑菌活性的影響。
1.2.8 胰蛋白酶酶解
?、倌z粒脫色:將目的條帶切成膠粒,分裝進1.5mL EP管中,使用50%ACN50% 50mmol/L NH4HCO3溶液脫色,②③④⑤⑥⑦膠粒脫水:加入100% ACN100μL,放置30min,待膠粒呈白色團狀,棄去ACN,室溫放置干燥。③還原烷基化:加入適量10mmol/L DTT于56℃水浴中還原1h,吸出棄去。而后加入適量55mmol/L IAA,暗處室溫反應1h,吸出棄去,按照①②步驟脫色脫水。④酶切:取10μL 5ng/μL酶于EP管中,4℃冰箱孵育40min,取出后每管補加5~10μL 50mmol/L NH4HCO3溶液,密封于37℃水浴中酶切16h⑤肽段提取,加提取液(5% TFA-50% ACN-45%水)100uL/管,37℃水浴1h,超聲5min,離心5mn,重復1次,真空離心干燥。
1.2.9 LC-MS/MS檢測
經胰蛋白酶酶解后的肽段在質譜儀中離子化后,通過檢測器分析,可得到各肽段的質荷比(m/z),即一級質譜圖;部分肽段再次被破碎和分析,產生二級質譜圖,采用質譜檢索軟件選擇Uniport蛋白數據庫,對獲得的全部質譜數據進行分析,色譜條件:流動相A:0.1%甲酸,2%ACN;流動相 B:0.1%甲酸,80% ACN;流速600nL/min;每個組分分析時間:66min。
1.3 數據統計分析
試驗數據采用SPSS 26.0軟件進行單因素方差分析采用LSD法對抑菌活性進行多重比較,采用Duncan’s法對理化特性各組數據進行多重比較,結果以平均值±標準差表示,P<0.05表示差異顯著。
2 結果
2.1 植物乳桿菌GX20200417-1生長曲線
由圖1可知,植物乳桿菌GX20200417-1在4h后D600nm值迅速上升,進入對數期,24h后趨于穩定,進入平臺期

2.2 植物乳桿菌抑菌活性測定
植物乳桿菌GX20200417-1對供試指示菌的抑菌活性見圖2.由圖2可知,植物乳桿菌GX20200417-1對沙門氏菌、大腸桿菌、金黃色葡萄球菌均具有較好的抑菌效果,其中對大腸桿菌的抑菌圈直徑大于沙門氏菌和金黃色葡萄球菌抑菌圈,直徑為13.33mm,說明植物乳桿菌GX20200417-1對大腸桿菌的抑菌效果優于沙門氏菌和金黃色葡萄球菌。

2.3 植物乳桿菌發酵上清液對大腸桿菌的抑制活性測定
由圖3可知,發酵液及發酵上清液的抑菌曲線基本相似且一致;在0~4h內沒有抑菌能力,4h后抑菌能力逐漸增強,并在24h時達到最大,此時發酵液及發酵上清液產生的抑菌圈直徑分別為13.33和12.21mm,隨著培養時間的延長,抑菌能力并無顯著變化。MRS培養基產生的抑菌圈直徑為0mm,對比圖1與圖3可發現,在4~24h范圍內,抑菌圈直徑與D600nm值增長趨勢一致,且在24時達到穩定。

2.4 胞外蛋白的制備及抑菌活性測定
將提取的胞外蛋白按比例稀釋于等體積發酵液的MRS培養基中,以保證單位體積的胞外蛋白全部來自于等體積下的菌液或等體積的發酵上清液。由圖4可知稀釋后的胞外蛋白與等體積的發酵液(1X108CFU/mL)及發酵上清液可產生相近直徑的抑菌圈,說明植物乳桿菌GX20200417-1胞外蛋白對于大腸桿菌亦具有較好的抑菌活性, 進一步說明植物乳桿菌代謝產物中的抑菌物質主要為抑菌蛋白成分,通過SDS-PAGE對提取的胞外蛋白進行分離,分離到胞外蛋白分子質量在5~150ku之間(圖5)。

2.5 抑菌蛋白理化特性
與對照組相比,胞外蛋白經20、40、60和80℃水浴處理后,抑菌活性均無顯著變化(P>0.05),但其在100和121℃處理后抑菌活性明顯下降,與對照組及其他溫度處理組差異顯著(P<0.05)(圖6)。不同pH緩沖液處理抑菌蛋白后,抑菌蛋白在pH為6.0~8.0的環境下,抑菌活性較好,與對照組相比,在過酸或過堿條件下抑菌活性均受到抑制(P<0.05)(圖7)。為驗證pH緩沖液本身是否對大腸桿菌產生抑菌影響,在pH分別為2.0~4.0和10.0~12.0的條件下對大腸桿菌做抑菌處理結果顯示,pH為2.0~4.0和10.0~12.0的無菌緩沖液均未對大腸桿菌產生抑菌影響(圖8)。與對照組相比,用蛋白酶K及胰蛋白酶處理抑菌蛋白后,抑菌蛋白抑菌活性顯著下降(P<0.05)(圖9)。

圖6溫度對抑菌蛋白活性的影響

2.6 抑菌蛋白的抑菌特性研究
為進一步研究抑菌蛋白的成分,用液相色譜串聯質譜分析儀進行分析,得到胞外蛋白總離子圖譜(圖10),質譜采集的數據,經過軟件MaxQuant(1.6.2.10)數據庫檢索,共檢測出5種可信度較高且與抑菌作用相關的蛋白質依次為片球菌素pediocinPA1、輔助蛋白、溶菌素、聚酮合酶和植物乳桿菌素(LysMpeptidoglycan-binding domain-containing protein)(表1)。Uniport蛋白數據庫功能預測顯示:pediocin PA-1為廣譜性的細菌素,溶菌素具有溶菌酶活性,二者主要通過破壞細菌細胞壁與細胞膜,從而達到抑菌效果。輔助蛋白主要參與細菌素的合成過程,聚酮合酶參與抗生素的合成。植物乳桿菌素(LysM peptidoglycan-binding domain-containing protein)在蛋白鑒定結果中顯示可信度最高。但在檢索數據庫中未顯示相關功能。

表1 植物乳桿菌GX20200417-1抑菌蛋白分析
|
蛋白 |
蛋白ID |
肽段 |
分子質量/KU |
序列長度 |
|
片球菌素 |
A0A6P1PE88 |
1 |
5.348 |
51 |
|
輔助蛋白 |
Q93FV5 |
9 |
6.348 |
174 |
|
溶菌素 |
A0A0R2GA25 |
4 |
7.348 |
434 |
|
聚酮合酶 |
A0A7G5YP34 |
1 |
8.348 |
1745 |
|
植物乳桿菌素 |
A0A7G5N5E7 |
10 |
19.662 |
187 |
3 討論
植物乳桿菌的主要益生特性之一是其廣譜的抑菌性,抑菌特性主要依賴于其產生的復雜代謝產物,包括有機酸、脂肪酸、抑菌蛋白或小分子抗菌肽等。國內外學者對抑菌蛋白的分離純化做了相關研究,分離純化方法主要有層析法、蒸發濃縮法、有機溶劑法、超濾法等。本研究采用低溫離心和超濾法分離植物乳桿菌代謝產物中的抑菌蛋白,并通過抑菌活性測定發現抑菌蛋白對大腸桿菌具有良好的抑菌效果,徐棟等從植物乳桿菌中分離出的細菌素 LZ222.以及翟佳琳等分離出的抑菌蛋白對大腸桿菌同樣具有抑菌活性,與之不同的是Todorov等分離出的細菌素ST26MS和ST28MS對大腸桿菌并無抑菌效果。本研究通過溫度、pH、酶處理等方法研究植物乳桿菌產生的抑菌蛋白的理化特性,發現抑菌蛋白具有較好的熱穩定性,經121℃處理后抑菌活性并未完全喪失;抑菌蛋白經不同 pH緩沖液處理后均能保持抑菌活性,且在pH為6.0~8.0時抑菌活性較強,本研究利用極酸極堿的無菌緩沖液對大腸桿菌做抑菌處理,證明緩沖液并未對大腸桿菌產生抑菌影響,這與在酸性條件下抑菌蛋白依然保持較高抑菌活性的結果相違背,與在堿性環境下抑菌活性減弱或喪失的結果保持一致,說明過酸過堿環境可能使抑菌蛋白的構象發生改變,對其活性產生影響。抑菌蛋白經胰蛋白酶、蛋白酶K處理后抑菌活性明顯減弱,可能是抑菌蛋白發生部分降解,這一結果與徐志嬌等分離出的抑菌蛋白及Seval等分離出的KT11的抑菌活性相似。
為進一步研究植物乳桿菌產生的抑菌蛋白的抑菌特性,通過LC-MS/MS分析鑒定出5種可信度較高且與抑菌作用相關的蛋白質,依次是片球菌素pediocin PA-1、輔助蛋白、溶菌素、聚酮合酶和植物乳桿菌素(LysM peptidoglycan-binding domain-containing protein)。
Pediocin PA-1是由51個氨基酸組成的細菌素,屬于植物乳桿菌產生的Class Ⅱa型細菌素,其殺菌機制主要是在細胞膜上形成孔洞,使細胞內離子外泄,引起質子驅動勢的耗散,最終引發病原菌死亡。Alvarez等證實細菌素以病原體的細胞膜為攻擊靶點,形成孔洞,導致內容物外泄,從而對大腸桿菌發揮抑菌作用。趙瑞香等發現細菌素作用大腸桿菌后細胞膜通透性增大,胞內K+和ATP大量外泄,細胞物質及能量代謝失衡,最終引發大腸桿菌死亡。已證實化學合成的pediocin PA-1可替代天然細菌素完成其抗菌功能。輔助蛋白是由174個氨基酸形成的小分子蛋白,主要功能是參與細菌素的生物合成,輔助蛋白具有高度的同源性,推測其具有輔助細菌素轉運的功能。
Lysin是由434個氨基酸形成的蛋白質,具有溶菌酶活性,通過水解細菌細胞壁的肽聚糖發揮其抗菌作用,殺菌活性高且耐藥性強,被認為是替抗產品的潛在候選蛋白,Li等發現高度嵌和的lysin對金黃色葡萄球菌在體內外均發揮抑菌活性。Chen等報道了一種獨特的lysin嵌合蛋白,該嵌合蛋白對多藥耐藥鮑曼不動桿菌的抑菌活性提高十萬倍左右。有關植物乳桿菌lysin的研究罕見報道,從植物乳桿菌GX20200417-1鑒定出的lysin可作為分離純化的重要方向。
聚酮合酶廣泛存在于植物、細菌和真菌中,是一類與次級代謝有著密切關系的酶類,催化合成結構多樣的聚酮化合物,具有良好的抗菌作用。根據 Uniport蛋白數據庫分析,植物乳桿菌代謝產物中的聚酮合酶能催化抗生素的生物合成,其對植物乳桿菌的抑菌效果發揮間接作用。
植物乳桿菌素(LysM peptidoglycan-binding domain-containing protein)是由187個氨基酸形成的小分子蛋白,質譜結果經Uinport數據庫比對,蛋白可信度最高。LysM結構域存在于許多細菌的肽聚糖水解酶中,主要作用機制是識別含有N-乙酰氨基葡萄糖(GlcNAc)殘基的肽聚糖,已有研究者在植物乳桿菌中鑒定出一種與免疫相關的葡聚糖水解酶即N-乙酰氨基葡糖苷酶(Acm2),葡聚糖水解酶C端含有3個重復的LysM結構域,研究證明LysM結構域通過與肽聚糖的結合識別病原菌,并通過某些未知的途徑調控抗菌肽的表達,從而起到有效的抑菌作用。
以上僅是分析鑒定出5種可信度較高的抑菌蛋白,并未對抑菌蛋白進一步分離得到單一物質,若對單一物質進行抑菌機理的深入研究,可為替抗產品的開發提供全新思路。
4 結 論
植物乳桿菌GX20200417-1抑菌譜廣,能有效抑制多種病原菌的增殖。本研究采用超濾法獲得其抑菌蛋白混合物,抑菌活性強,具有較好的耐熱、耐酸堿性,在pH 6.0~8.0時抑菌活性最佳,對蛋白酶敏感。利用LC-MS/MS分析鑒定出5種可信度較高且與抑菌作用相關的蛋白質,蛋白功能分析顯示,這些抑菌蛋白可通過破壞細菌細胞膜及細胞壁直接或間接發揮抑菌作用。本研究對抑菌蛋白的分離及抑菌機制的解析可為新型抗菌制劑的開發提供參考。
參考文獻:略。

-
[02-02]
-
[01-26]
-
[01-19]
-
[01-12]
-
[01-05]
-
[12-22]
-
[10-13]
-
[10-08]
-
[09-22]
-
[09-15]



